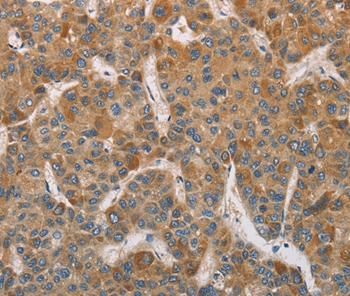
product-image-AAA301440_IHC13.jpg
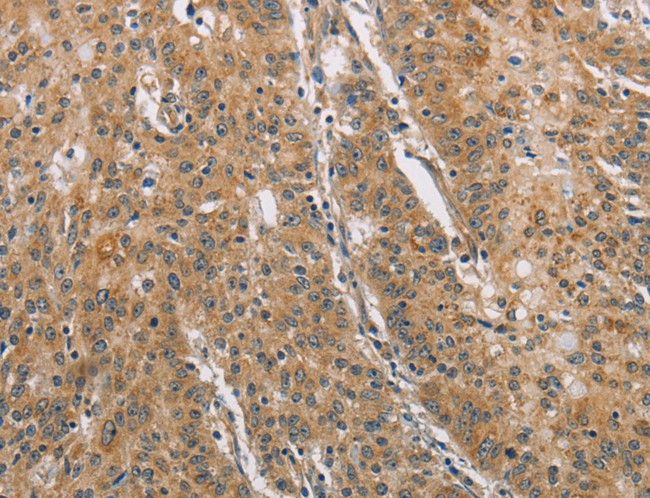
product-image-AAA167713_IHC11.jpg

Probable ATP-dependent RNA helicase DDX53 (DDX53) Recombinant Protein | DDX53 recombinant protein
Recombinant Human Probable ATP-dependent RNA helicase DDX53 (DDX53)
Gene Names
DDX53; CAGE; CT26
Purity
Greater or equal to 85% purity as determined by SDS-PAGE.
Synonyms
Probable ATP-dependent RNA helicase DDX53 (DDX53); N/A; Recombinant Human Probable ATP-dependent RNA helicase DDX53 (DDX53); DDX53 recombinant protein
Host
E Coli or Yeast or Baculovirus or Mammalian Cell
Purity/Purification
Greater or equal to 85% purity as determined by SDS-PAGE.
Form/Format
Lyophilized or liquid (Format to be determined during the manufacturing process)
Sequence Positions
1-631aa; Full Length
Sequence
MSHWAPEWKRAEANPRDLGASWDVRGSRGSGWSGPFGHQGPRAAGSREPPLCFKIKNNMVGVVIGYSGSKIKDLQHSTNTKIQIINGESEAKVRIFGNREMKAKAKAAIETLIRKQESYNSESSVDNAASQTPIGRNLGRNDIVGEAEPLSNWDRIRAAVVECEKRKWADLPPVKKNFYIESKATSCMSEMQVINWRKENFNITCDDLKSGEKRLIPKPTCRFKDAFQQYPDLLKSIIRVGIVKPTPIQSQAWPIILQGIDLIVVAQTGTGKTLSYLMPGFIHLDSQPISREQRNGPGMLVLTPTRELALHVEAECSKYSYKGLKSICIYGGRNRNGQIEDISKGVDIIIATPGRLNDLQMNNSVNLRSITYLVIDEADKMLDMEFEPQIRKILLDVRPDRQTVMTSATWPDTVRQLALSYLKDPMIVYVGNLNLVAVNTVKQNIIVTTEKEKRALTQEFVENMSPNDKVIMFVSQKHIADDLSSDFNIQGISAESLHGNSEQSDQERAVEDFKSGNIKILITTDIVSRGLDLNDVTHVYNYDFPRNIDVYVHRVGYIGRTGKTGTSVTLITQRDSKMAGELIKILDRANQSVPEDLVVMAEQYKLNQQKRHRETRSRKPGQRRKEFYFLS
Species
Homo sapiens (Human)
Preparation and Storage
Store at -20 degrees C. For long-term storage, store at -20 degrees C or -80 degrees C. Store working aliquots at 4 degrees C for up to one week. Repeated freezing and thawing is not recommended.
Product Categories/Family for DDX53 recombinant protein
References
"Promoter hypomethylation of a novel cancer testis antigen gene CAGE is correlated with its aberrant expression and is seen in premalignant stage of gastric carcinoma." Cho B., Lee H., Jeong S., Bang Y.J., Lee H.J., Hwang K.S., Kim H.Y., Lee Y.S., Kang G.H., Jeoung D.I. Biochem. Biophys. Res. Commun. 307:52-63(2003)
NCBI and Uniprot Product Information
NCBI GI #
NCBI GeneID
NCBI Accession #
NCBI GenBank Nucleotide #
Molecular Weight
76.2 kDa
NCBI Official Full Name
DEAD box protein 53
NCBI Official Synonym Full Names
DEAD-box helicase 53
NCBI Official Symbol
DDX53
NCBI Official Synonym Symbols
CAGE; CT26
NCBI Protein Information
DEAD box protein 53
UniProt Protein Name
Probable ATP-dependent RNA helicase DDX53
UniProt Gene Name
DDX53
UniProt Synonym Gene Names
CAGE; CT26
Customer Reviews
Loading reviews...
Share Your Experience
Similar Products
Product Notes
The DDX53 ddx53 (Catalog #AAA18764) is a Recombinant Protein produced from E Coli or Yeast or Baculovirus or Mammalian Cell and is intended for research purposes only. The product is available for immediate purchase. The immunogen sequence is 1-631aa; Full Length. The amino acid sequence is listed below: MSHWAPEWKR AEANPRDLGA SWDVRGSRGS GWSGPFGHQG PRAAGSREPP LCFKIKNNMV GVVIGYSGSK IKDLQHSTNT KIQIINGESE AKVRIFGNRE MKAKAKAAIE TLIRKQESYN SESSVDNAAS QTPIGRNLGR NDIVGEAEPL SNWDRIRAAV VECEKRKWAD LPPVKKNFYI ESKATSCMSE MQVINWRKEN FNITCDDLKS GEKRLIPKPT CRFKDAFQQY PDLLKSIIRV GIVKPTPIQS QAWPIILQGI DLIVVAQTGT GKTLSYLMPG FIHLDSQPIS REQRNGPGML VLTPTRELAL HVEAECSKYS YKGLKSICIY GGRNRNGQIE DISKGVDIII ATPGRLNDLQ MNNSVNLRSI TYLVIDEADK MLDMEFEPQI RKILLDVRPD RQTVMTSATW PDTVRQLALS YLKDPMIVYV GNLNLVAVNT VKQNIIVTTE KEKRALTQEF VENMSPNDKV IMFVSQKHIA DDLSSDFNIQ GISAESLHGN SEQSDQERAV EDFKSGNIKI LITTDIVSRG LDLNDVTHVY NYDFPRNIDV YVHRVGYIGR TGKTGTSVTL ITQRDSKMAG ELIKILDRAN QSVPEDLVVM AEQYKLNQQK RHRETRSRKP GQRRKEFYFL S . It is sometimes possible for the material contained within the vial of "Probable ATP-dependent RNA helicase DDX53 (DDX53), Recombinant Protein" to become dispersed throughout the inside of the vial, particularly around the seal of said vial, during shipment and storage. We always suggest centrifuging these vials to consolidate all of the liquid away from the lid and to the bottom of the vial prior to opening. Please be advised that certain products may require dry ice for shipping and that, if this is the case, an additional dry ice fee may also be required.Precautions
All products in the AAA Biotech catalog are strictly for research-use only, and are absolutely not suitable for use in any sort of medical, therapeutic, prophylactic, in-vivo, or diagnostic capacity. By purchasing a product from AAA Biotech, you are explicitly certifying that said products will be properly tested and used in line with industry standard. AAA Biotech and its authorized distribution partners reserve the right to refuse to fulfill any order if we have any indication that a purchaser may be intending to use a product outside of our accepted criteria.Disclaimer
Though we do strive to guarantee the information represented in this datasheet, AAA Biotech cannot be held responsible for any oversights or imprecisions. AAA Biotech reserves the right to adjust any aspect of this datasheet at any time and without notice. It is the responsibility of the customer to inform AAA Biotech of any product performance issues observed or experienced within 30 days of receipt of said product. To see additional details on this or any of our other policies, please see our Terms & Conditions page.Item has been added to Shopping Cart
If you are ready to order, navigate to Shopping Cart and get ready to checkout.